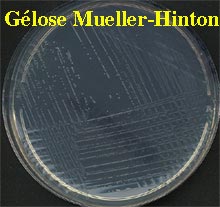

|
 |
Pour cette bactérie ubiquiste, largement répandue dans la nature !!!!!

Le diagnostic chez l'homme est évoqué dans un contexte clinique particulier
FORMES CLINIQUES

 |
 |
Il s'agit d'une maladie à déclaration obligatoire d'autant que l'ingestion est le mode de contamination le plus fréquent chez l'homme, d'où la notion d'épidémie.

1/DIAGNOSTIC BACTERIOLOGIQUE
Prélèvements :
Chez la femme enceinte, pratiquer une hémoculture devant toute fièvre, amniocentèse par voie trans-abdominale, lochies utérines avant et après accouchement, fragment placentaire, méconium (enfant) avec ou sans écouvillonnage rectal, sécrétions nasales, pharyngées, conjonctivales, liquide gastrique, LCR.......
Chez l'adulte : sang, LCR
|
Examen direct :
LCR : Aspect cytologique de type panaché avec polynucléaires et lymphocytes ou méningite à liquide clair. Petit bacille à Gram positif de 0,5 à 1,2 µm. Peut être confondu avec un streptocoque, non sporulé, intra/extracellulaire. Si décoloration importante, confondu avecHaemophilus. |
 |
Culture-Isolement :
* Milieux classiques : hémoculture, bouillon nutritif glucosé à 0,5 % (LCR), gélose ordinaire ou à 5 % de sang frais, supplémenté ou non en acide nalidixique ANC (bioMérieux).
|
* Autres milieux pour les produits d'origine alimentaire : Certains bouillons permettent un enrichissement en 48 h à 22-25° C. Divers milieux peuvent contenir des agents inhibiteurs: acriflavine, acide nalidixique, thiocyanate de potassium , colistine, ceftazidime, cycloheximide, latamoxef, cefotetan, fosfomycine.......
* Incubation 24 h à 37°C et en atmosphère normale ou dans une atmosphère enrichie en C02 (bougie ou sachet Gaspack, bioMérieux). |
 |
* Colonies ß-hémolytiques caractéristiques (zone d'hémolyse complète, le plus souvent étroite)

* Sur gélose nutritive, colonies convexes à bords réguliers et translucides avec une coloration bleu-vert caractéristique (transillumination oblique).
|
 |
|
Identification (orientation) :
* Catalase + oxydase - * Hydrolyse rapide de l'esculine en 2-3 heures |
  |
* Mobilité : ensemencer deux bouillons nutritifs et incuber à 20-25° C et à 35-37° C pendant 4 heures.
En gélose mobilité, il y a une image typique de sapin renversé (microaérophile) à 25° C.

* Ensemencer une galerie : api LISTERIA (bioMérieux) ou à défaut, api CORYNE



* Le CAMP-test est réservé à quelques laboratoires
Pour confirmation de l'identification et la surveillance épidémiologique
Adresser la souche au Centre National de Référence (CNR)

Laboratoire des Listeria : Dr. J. Rocourt, Ch. Jacquet
Diverses études épidémiologiques permettent d'établir la tracabilité des souches (épidémie)
- sérovar (agglutination sur lame avec sérums monospécifiques)
- lysotype (suspensions de bactériophages)
 |
 |
- typage moléculaire (ADN en champ pulsé)

Antibiogramme :
* En pratique, utiliser la méthode de diffusion en gélose Mueller-Hinton supplémentée avec 5 % de sang ou non.
* Tester les antibiotiques suivants: pénicilline G, amoxicilline, gentamicine, tétracycline, érythromycine, chloramphénicol, triméthoprime-sulfaméthoxazole.
La sensibilité ou résistance naturelle à certains antibiotiques est une aide à l'identification : glycopeptides, lincomycine, clindamycine, quinolones, mecillinam et céphalosporines de troisième génération (C3G), fosfomycine, colistine...............
* Incuber 18 h à 37°C en atmosphère normale
Confondue quelquefois avec une souche de streptocoque (bacille court catalase -), l'antibiotype de L. monocytogenes présente des similitudes avec les entérocoques.
 |
 |
Le diagnostic différentiel portera sur la sensibilité habituelle aux aminoglycosides (disques faiblemant chargés)

Le reste de l'antibiotype est caractéristique d'un bacille à Gram-positif en raison de la résistance naturelle à certains antibiotiques :
mecillinam et céphalosporines de troisième génération
 |
 |
quinolones, voire anciennes fluoroquinolones, colistine

fosfomycine

2/ DIAGNOSTIC PAR AMPLIFICATION GENIQUE (PCR)
L'utilisation de la PCR (Polymerase Chain Reaction) est encore d'intérêt très limité.
3/ SERODIAGNOSTIC (laboratoire spécialisé) : Celui-ci n'est pas pris en considération dans la surveillance, contrairement au diagnostic bactériologique.
Deux types de tests :
- anticorps contre les bactéries tuées (séroagglutination)
- anticorps anti-listériolysine 0 (LLO) (Dot blot)(Hôpital Necker-Enfants Malades)
Indications :
- sans intérêt si germe isolé
- appoint au diagnostic si suspicion dans :
* listériose au cours d'une grossesse fébrile
* rhombencéphalite sans germe
Titres
- Anticorps agglutinants : 1/320 -1/640 > 10 jours d'infection,
- Anticorps anti-listériolysine 0 (LLO) : 1/100-1/5000 dans infection aiguë
* Si négatif : nouveau test à 15 jours d'intervalle

* Si séroconversion : en faveur d'une infection grave
4/ PRELEVEMENTS ALIMENTAIRES
La recherche de cette bactérie dans divers produits d'origine alimentaire met en oeuvre divers procédés dont l'objectif est, le plus souvent, une détection rapide bien que diverses méthodes d'enrichissement soient aussi utilisées : Méthode ELISA, cytofluorométrie, utilisation de sondes basées sur l'ARN ou le gène de l'hémolysine ou encore PCR amplifiant des gènes codant pour des facteurs impliqués dans le pathogénicité de la bactérie sont actuellement utilisées ou en cours d'évaluation.
Cette fiche a été préparée avec la collaboration de J. Rocourt (Institut Pasteur) et P. Berche (Hôpital Necker-Enfants malades, Université Paris V) 15/04/1999
|
|
|
|
|